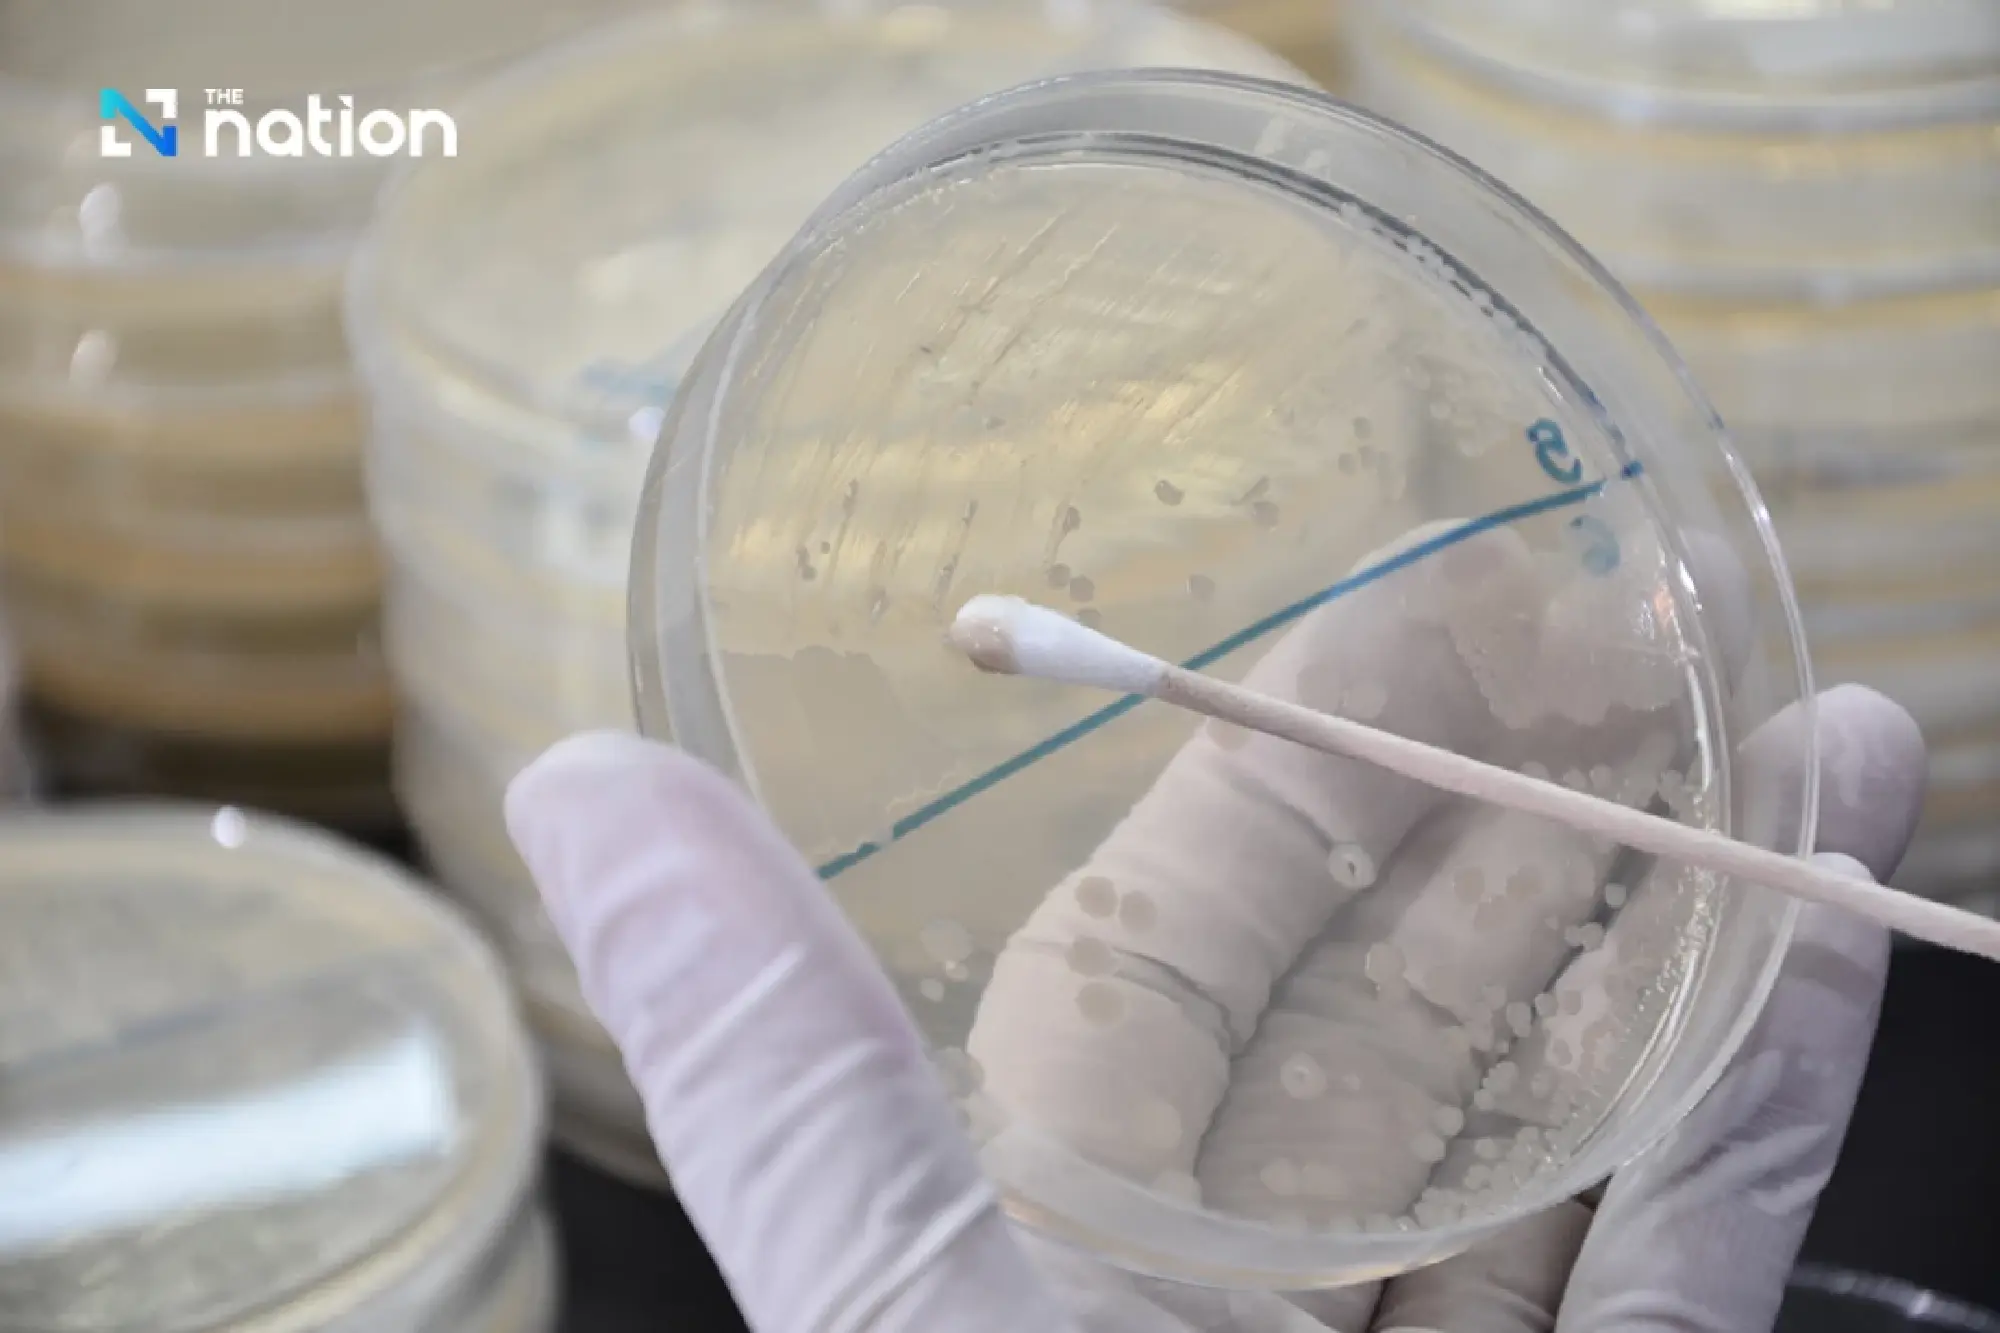
Department of Medical Sciences reveals fungal and Clostridium contamination in Thai herbal inhaler product

Department of Medical Sciences warns against potential health risks from fungal and Clostridium perfringens contamination in a Thai herbal inhaler product, urging manufacturers to improve microbial safety
Dr. Sarawut Boonsuk, M.D., Director-General of the Department of Medical Sciences, disclosed that the Food and Drug Administration (FDA) had collected samples of the Thai Herbal Inhaler brand "Hong Thai," registration number G 309/62, production batch 000332. The Department of Medical Sciences received two samples from the FDA for testing: the first batch in June, with results in July, and the second in August, with results reported in September. The test results showed that the product did not meet standards for microbial contamination, including the total yeast and mold count, and contamination by Clostridium species. Further confirmation identified the contaminant as Clostridium perfringens.

Dr. Sarawut explained that the tests were conducted using the British Pharmacopoeia standard methods and the Thai Herbal Pharmacopoeia standards, in accordance with the Ministry of Public Health's regulations on the purity and other essential characteristics of registered herbal products, as outlined in the 2021 public health announcement.
The microbial contamination testing criteria are as follows:
- Total microbial growth in the air should not exceed 200 colonies per gram.
- Total yeast and mold count should not exceed 20 colonies per gram.
- Specific microorganisms such as Staphylococcus aureus, Pseudomonas aeruginosa, and Clostridium species should not be present.
The test for total microbial growth and yeast/mold count was carried out using the plate count method, which involves culturing the contaminated sample on agar plates and counting the number of colonies that develop. For specific microbial detection, the method involved increasing the number of pathogens in liquid culture, isolating them using specific culture media, and performing staining and microscopic examination.
Dr. Sarawut further noted that, in the fiscal year 2025, 54 samples of herbal inhalers were submitted for testing to the Department of Medical Sciences. Of these, 39 samples failed to meet standards, primarily due to excessive microbial growth and Clostridium contamination. These findings have been communicated to the relevant authorities for further action.
He also stated that Clostridium perfringens, which is commonly found in soil, thrives in anaerobic conditions. Inhalation of spores from fungi and Clostridium perfringens can be harmful, especially for individuals with weakened immune systems, the elderly, or those with pre-existing health conditions. Inhalation may lead to respiratory issues such as difficulty breathing, wheezing, coughing, and sore throat, with possible blood in saliva and sputum.
Therefore, it is recommended that manufacturers eliminate or reduce microbial contamination before processing herbal products, using methods such as washing, baking, or irradiation. The Department of Medical Sciences is ready to support small-scale producers in quality control checks prior to registration to ensure safe and high-quality products for consumers.

